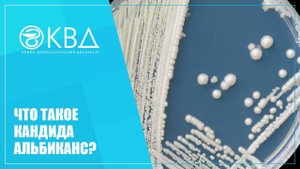
✅ Что такое Кандида альбиканс

2:49
2:49
2024-07-24 22:05

 2:06
2:06

 2:06
2:06
2024-01-24 08:18

 4:25
4:25

 4:25
4:25
2024-07-10 12:48

 1:29:24
1:29:24

 1:29:24
1:29:24
2025-01-09 17:03

 1:06:06
1:06:06

 1:06:06
1:06:06
2025-02-18 00:46

 22:08
22:08

 22:08
22:08
2024-01-23 12:52

 3:54:59
3:54:59

 3:54:59
3:54:59
2024-04-20 21:03

 4:57
4:57

 4:57
4:57
2023-12-31 19:55

 2:31
2:31

 2:31
2:31
2023-12-28 10:47

 10:21
10:21

 10:21
10:21
2025-01-11 21:00

 1:59
1:59

 1:59
1:59
2025-06-02 04:39

 2:47
2:47

 2:47
2:47
2023-05-19 20:56

 8:00
8:00

 8:00
8:00
2023-11-01 00:14

 3:32
3:32

 3:32
3:32
2023-10-01 14:42

 13:12
13:12

 13:12
13:12
2023-10-01 18:00

 1:52
1:52

 1:52
1:52
2023-09-11 01:06

 11:23
11:23
11:23
11:23
2022-03-10 14:55

 11:25
11:25
![Ольга Бузова - Не надо (Премьера клипа 2025)]() 3:15
3:15
![Артур Халатов - Девочка моя (Премьера клипа 2025)]() 2:37
2:37
![Анна Бершадская - Новая я (Премьера клипа 2025)]() 2:41
2:41
![Рейсан Магомедкеримов, Ренат Омаров - Бла-та-та (Премьера клипа 2025)]() 2:26
2:26
![Азиз Абдуллох - Аллохнинг айтгани булади (Премьера клипа 2025)]() 3:40
3:40
![SERYABKINA, Брутто - Светофоры (Премьера клипа 2025)]() 3:49
3:49
![Дана Лахова - Одинокая луна (Премьера клипа 2025)]() 2:15
2:15
![Жасурбек Мирзажонов - Суймаганга суйкалдим (Премьера клипа 2025)]() 5:45
5:45
![Фаррух Хамраев - Отажоним булсайди (Премьера клипа 2025)]() 3:08
3:08
![Сергей Сухачёв - Розовый туман (Премьера клипа 2025)]() 3:13
3:13
![Зара - Танго о двух влюбленных кораблях (Премьера клипа 2025)]() 3:10
3:10
![Шерзодбек Жонибеков - Дадажон (Премьера клипа 2025)]() 3:02
3:02
![Светлана Ларионова - Осень отстой (Премьера клипа 2025)]() 3:30
3:30
![Сергей Одинцов - Девочка любимая (Премьера клипа 2025)]() 3:56
3:56
![Жалолиддин Ахмадалиев - Тонг отгунча (Премьера клипа 2025)]() 4:44
4:44
![Игорь Крутой - Зонтик (Премьера клипа 2025)]() 4:00
4:00
![Хабибулло Хамроз - Хуп деб куёринг (Премьера клипа 2025)]() 4:04
4:04
![INSTASAMKA - BOSS (Премьера клипа 2025)]() 3:41
3:41
![Рустам Нахушев, Зульфия Чотчаева - Каюсь (Премьера клипа 2025)]() 3:20
3:20
![MEDNA - Алё (Премьера клипа 2025)]() 2:28
2:28
![Чумовая пятница 2 | Freakier Friday (2025)]() 1:50:38
1:50:38
![Диспетчер | Relay (2025)]() 1:51:56
1:51:56
![Элис, дорогая | Alice, Darling (2022)]() 1:29:30
1:29:30
![Терминатор 2: Судный день | Terminator 2: Judgment Day (1991) (Гоблин)]() 2:36:13
2:36:13
![Счастливчик Гилмор 2 | Happy Gilmore (2025)]() 1:57:36
1:57:36
![Когда ты закончишь спасать мир | When You Finish Saving the World (2022)]() 1:27:40
1:27:40
![Никто 2 | Nobody 2 (2025)]() 1:29:27
1:29:27
![Тот самый | Him (2025)]() 1:36:20
1:36:20
![Мужчина у меня в подвале | The Man in My Basement (2025)]() 1:54:48
1:54:48
![Дом из динамита | A House of Dynamite (2025)]() 1:55:08
1:55:08
![Псы войны | Hounds of War (2024)]() 1:34:38
1:34:38
![Французский любовник | French Lover (2025)]() 2:02:20
2:02:20
![Государственный гимн | Americana (2025)]() 1:47:31
1:47:31
![Богомол | Samagwi (2025)]() 1:53:29
1:53:29
![Стив | Steve (2025)]() 1:33:34
1:33:34
![Голый пистолет | The Naked Gun (2025)]() 1:26:24
1:26:24
![Плохой Cанта 2 | Bad Santa 2 (2016) (Гоблин)]() 1:28:32
1:28:32
![Лос-Анджелес в огне | Kings (2017)]() 1:29:27
1:29:27
![Пойман с поличным | Caught Stealing (2025)]() 1:46:45
1:46:45
![Девушка из каюты №10 | The Woman in Cabin 10 (2025)]() 1:35:11
1:35:11
![Приключения Тайо]() 12:50
12:50
![Таинственные золотые города]() 23:04
23:04
![Хвостатые песенки]() 7:00
7:00
![Папа Супергерой Сезон 1]() 4:28
4:28
![Панда и петушок Лука]() 12:12
12:12
![Последний книжный магазин]() 11:20
11:20
![Отважные мишки]() 13:00
13:00
![Космический рейнджер Роджер Сезон 1]() 11:32
11:32
![Сборники «Простоквашино»]() 1:04:60
1:04:60
![Ну, погоди! Каникулы]() 7:09
7:09
![Котёнок Шмяк]() 11:04
11:04
![Забавные медвежата]() 13:00
13:00
![Сборники «Зебра в клеточку»]() 45:30
45:30
![Пингвиненок Пороро]() 7:42
7:42
![Пакман в мире привидений]() 21:37
21:37
![Поймай Тинипин! Королевство эмоций]() 12:24
12:24
![Тодли Великолепный!]() 3:15
3:15
![Тёплая анимация | Новая авторская анимация Союзмультфильма]() 10:21
10:21
![Чемпионы]() 7:21
7:21
![Игрушечный полицейский Сезон 1]() 7:19
7:19

 11:25
11:25Скачать видео
| 256x144 | ||
| 432x232 | ||
| 640x360 | ||
| 856x480 | ||
| 1280x720 |
 3:15
3:15
2025-10-18 10:02
 2:37
2:37
2025-10-28 10:22
 2:41
2:41
2025-10-22 14:02
 2:26
2:26
2025-10-22 14:10
 3:40
3:40
2025-10-18 10:34
 3:49
3:49
2025-10-25 12:52
 2:15
2:15
2025-10-22 14:16
 5:45
5:45
2025-10-27 13:06
 3:08
3:08
2025-10-18 10:28
 3:13
3:13
2025-10-24 12:18
 3:10
3:10
2025-10-27 10:52
 3:02
3:02
2025-10-25 13:03
 3:30
3:30
2025-10-24 11:42
 3:56
3:56
2025-10-28 11:02
 4:44
4:44
2025-10-19 10:46
 4:00
4:00
2025-10-18 10:19
 4:04
4:04
2025-10-28 13:40
 3:41
3:41
2025-10-23 13:04
 3:20
3:20
2025-10-30 10:39
 2:28
2:28
2025-10-21 09:22
0/0
 1:50:38
1:50:38
2025-10-16 16:08
 1:51:56
1:51:56
2025-09-24 11:35
 1:29:30
1:29:30
2025-09-11 08:20
 2:36:13
2:36:13
2025-10-07 09:27
 1:57:36
1:57:36
2025-08-21 17:43
 1:27:40
1:27:40
2025-08-27 17:17
 1:29:27
1:29:27
2025-09-07 22:44
 1:36:20
1:36:20
2025-10-09 20:02
 1:54:48
1:54:48
2025-10-01 15:17
 1:55:08
1:55:08
2025-10-29 16:30
 1:34:38
1:34:38
2025-08-28 15:32
 2:02:20
2:02:20
2025-10-01 12:06
 1:47:31
1:47:31
2025-09-17 22:22
 1:53:29
1:53:29
2025-10-01 12:06
 1:33:34
1:33:34
2025-10-08 12:27
 1:26:24
1:26:24
2025-09-03 13:20
 1:28:32
1:28:32
2025-10-07 09:27
 1:29:27
1:29:27
2025-08-28 15:32
 1:46:45
1:46:45
2025-10-02 20:45
 1:35:11
1:35:11
2025-10-13 12:06
0/0
 12:50
12:50
2024-12-17 13:25
 23:04
23:04
2025-01-09 17:26
 7:00
7:00
2025-06-01 11:15
2021-09-22 21:52
 12:12
12:12
2024-11-29 14:21
 11:20
11:20
2025-09-12 10:05
 13:00
13:00
2024-11-29 13:39
2021-09-22 21:49
 1:04:60
1:04:60
2025-09-02 13:47
 7:09
7:09
2025-08-19 17:20
 11:04
11:04
2023-05-18 16:41
 13:00
13:00
2024-12-02 13:15
 45:30
45:30
2025-09-17 18:49
 7:42
7:42
2024-12-17 12:21
 21:37
21:37
2024-11-28 17:35
 12:24
12:24
2024-11-27 13:24
 3:15
3:15
2025-06-10 13:56
 10:21
10:21
2025-09-11 10:05
 7:21
7:21
2025-10-07 09:00
2021-09-22 21:03
0/0

